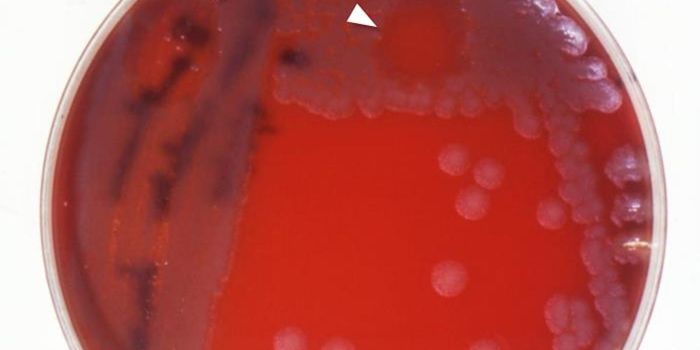
The Structure of a Bacteriophage DNA Tube is Revealed

DNA Virus
A DNA virus is a type of virus that has DNA as genetic material. DNA viruses usually contain double-stranded DNA and use DNA-dependent DNA polymerase to replicate. In contrast to RNA viruses, which have smaller genomes, DNA viruses can encode hundreds of viral proteins once inside the host. Another difference between DNA and RNA viruses is that DNA viruses undertake their replication within the infected cell's nucleus, whereas RNA viruses replicate in the cytoplasm of infected cells. Examples of DNA viruses include the herpesviruses (which cause chickenpox, shingles, and oral and genital herpes), the smallpox viruses, adenoviruses (which cause common colds), and papillomaviruses (such as HPV).
-
JUN 01, 2021Genetics & GenomicsViral surveillance can give researchers vital information about virus origins, transmission routes, affected popu ...Sponsored By: Integrated DNA Technologies, Inc.MAY 06, 2021Genetics & GenomicsPlants and animals have genomes made of four nucleotide bases, adenine (A), thymine (T), cytosine (C), and guanine (G). ...Written By: Carmen LeitchAPR 28, 2021Cell & Molecular BiologySugar is something sweet to add to your food, but just like fat, different types of sugars play important roles in biolo ...Written By: Carmen LeitchAPR 25, 2021Cell & Molecular BiologyWhen we're exposed to a pathogen, our immune system normally mounts a robust response against it. Antibodies are generat ...Written By: Carmen LeitchAPR 11, 2021Genetics & GenomicsVaccines are mostly known as tools to prevent illness. But cancer vaccines are a bit different, and aim to treat existin ...Written By: Carmen LeitchMAR 30, 2021Genetics & GenomicsBacteria can share genetic material in a process called horizontal gene transfer, and recent work has shown that in anim ...Written By: Carmen LeitchMAR 23, 2021Genetics & GenomicsDr. John-Sebastian Eden is a Virologist at the Westmead Institute for Medical Research in Sydney, Australia. His group u ...MAR 18, 2021MicrobiologyHepatitis B can cause a long-term and sometimes fatal disease. Princeton University researchers have learned more about ...Written By: Carmen LeitchMAR 02, 2021Cell & Molecular BiologyRetroviruses can infect cells and insert themselves into the genetic code of their host. Sometime in the past 50,000 yea ...Written By: Carmen LeitchFEB 24, 2021MicrobiologyUsing metagenomics tools, which sequence all of the viral material in a sample, researchers have investigated the viruse ...Written By: Carmen LeitchFEB 02, 2021Clinical & Molecular DXContact tracing is a powerful tool used by public health authorities to help slow the spread of infectious diseases such ...Written By: Tara FernandesJAN 25, 2021MicrobiologyThe advancement of genetic and computational tools has given us so much new information its opened up new research field ...Written By: Carmen LeitchDEC 23, 2020Clinical & Molecular DXQuick, portable, and ultrasensitive—a new smartphone test for COVID-19 checks all the boxes needed to get a handle ...Written By: Tara FernandesDEC 20, 2020MicrobiologyScientist Katalin Karikó studied mRNA vaccines for years. She spent years getting grant rejections, but has now helped c ...Written By: Carmen LeitchNOV 18, 2020MicrobiologyFive people in Bolivia are known to have been infected with the Chapare virus, which causes hemorrhagic fever. Some infe ...Written By: Carmen LeitchNOV 17, 2020ImmunologyLast year, around 1.7 million people became infected with HIV, with around half of these being women. Encouraging result ...Written By: Tara FernandesNOV 15, 2020MicrobiologyHubrecht Institute researchers observe a virus as it invades a cell and competes with the host for control of the host c ...Written By: Carmen LeitchNOV 14, 2020MicrobiologySome viruses only infect bacteria; they care called bacteriophages or phages for short. As antibiotic-resistant bacteria ...Written By: Carmen LeitchNOV 12, 2020Genetics & GenomicsTo repair disease-causing errors in the genome, gene editing reagents like those used in CRISPR-Cas9 first have to reach ...Written By: Carmen LeitchNOV 10, 2020ImmunologyIn the middle of 2020, yet another deadly Ebola outbreak was reported in the Democratic Republic of the Congo - the 11th ...Written By: Tara FernandesOCT 19, 2020Cell & Molecular BiologyTo learn more about biology and medicine, researchers have used advances in molecular techniques and computational biolo ...Written By: Carmen LeitchOCT 04, 2020MicrobiologyNot all viruses affect animal cells; some viruses can infect bacteria. Humans are known to carry vast numbers of microor ...Written By: Carmen LeitchSEP 23, 2020MicrobiologyPoxviruses are deadly viruses that are known to infect both animals and humans. Cowpox and monkeypox are both known to s ...Written By: Carmen LeitchSEP 07, 2020Cell & Molecular BiologyIf you've ever been through a battery of tests while doctors try to find a diagnosis for an ailment, you know that many ...Written By: Carmen Leitch
JUN 01, 2021
Genetics & Genomics
Viral surveillance can give researchers vital information about virus origins, transmission routes, affected popu
...
Sponsored By:
Integrated DNA Technologies, Inc.
MAY 06, 2021
Genetics & Genomics
Plants and animals have genomes made of four nucleotide bases, adenine (A), thymine (T), cytosine (C), and guanine (G).
...
Written By:
Carmen Leitch
APR 28, 2021
Cell & Molecular Biology
Sugar is something sweet to add to your food, but just like fat, different types of sugars play important roles in biolo
...
Written By:
Carmen Leitch
APR 25, 2021
Cell & Molecular Biology
When we're exposed to a pathogen, our immune system normally mounts a robust response against it. Antibodies are generat
...
Written By:
Carmen Leitch
APR 11, 2021
Genetics & Genomics
Vaccines are mostly known as tools to prevent illness. But cancer vaccines are a bit different, and aim to treat existin
...
Written By:
Carmen Leitch
MAR 30, 2021
Genetics & Genomics
Bacteria can share genetic material in a process called horizontal gene transfer, and recent work has shown that in anim
...
Written By:
Carmen Leitch
MAR 23, 2021
Genetics & Genomics
Dr. John-Sebastian Eden is a Virologist at the Westmead Institute for Medical Research in Sydney, Australia. His group u
...
MAR 18, 2021
Microbiology
Hepatitis B can cause a long-term and sometimes fatal disease. Princeton University researchers have learned more about
...
Written By:
Carmen Leitch
MAR 02, 2021
Cell & Molecular Biology
Retroviruses can infect cells and insert themselves into the genetic code of their host. Sometime in the past 50,000 yea
...
Written By:
Carmen Leitch
FEB 24, 2021
Microbiology
Using metagenomics tools, which sequence all of the viral material in a sample, researchers have investigated the viruse
...
Written By:
Carmen Leitch
FEB 02, 2021
Clinical & Molecular DX
Contact tracing is a powerful tool used by public health authorities to help slow the spread of infectious diseases such
...
Written By:
Tara Fernandes
JAN 25, 2021
Microbiology
The advancement of genetic and computational tools has given us so much new information its opened up new research field
...
Written By:
Carmen Leitch
DEC 23, 2020
Clinical & Molecular DX
Quick, portable, and ultrasensitive—a new smartphone test for COVID-19 checks all the boxes needed to get a handle
...
Written By:
Tara Fernandes
DEC 20, 2020
Microbiology
Scientist Katalin Karikó studied mRNA vaccines for years. She spent years getting grant rejections, but has now helped c
...
Written By:
Carmen Leitch
NOV 18, 2020
Microbiology
Five people in Bolivia are known to have been infected with the Chapare virus, which causes hemorrhagic fever. Some infe
...
Written By:
Carmen Leitch
NOV 17, 2020
Immunology
Last year, around 1.7 million people became infected with HIV, with around half of these being women. Encouraging result
...
Written By:
Tara Fernandes
NOV 15, 2020
Microbiology
Hubrecht Institute researchers observe a virus as it invades a cell and competes with the host for control of the host c
...
Written By:
Carmen Leitch
NOV 14, 2020
Microbiology
Some viruses only infect bacteria; they care called bacteriophages or phages for short. As antibiotic-resistant bacteria
...
Written By:
Carmen Leitch
NOV 12, 2020
Genetics & Genomics
To repair disease-causing errors in the genome, gene editing reagents like those used in CRISPR-Cas9 first have to reach
...
Written By:
Carmen Leitch
NOV 10, 2020
Immunology
In the middle of 2020, yet another deadly Ebola outbreak was reported in the Democratic Republic of the Congo - the 11th
...
Written By:
Tara Fernandes
OCT 19, 2020
Cell & Molecular Biology
To learn more about biology and medicine, researchers have used advances in molecular techniques and computational biolo
...
Written By:
Carmen Leitch
OCT 04, 2020
Microbiology
Not all viruses affect animal cells; some viruses can infect bacteria. Humans are known to carry vast numbers of microor
...
Written By:
Carmen Leitch
SEP 23, 2020
Microbiology
Poxviruses are deadly viruses that are known to infect both animals and humans. Cowpox and monkeypox are both known to s
...
Written By:
Carmen Leitch
SEP 07, 2020
Cell & Molecular Biology
If you've ever been through a battery of tests while doctors try to find a diagnosis for an ailment, you know that many
...
Written By:
Carmen Leitch